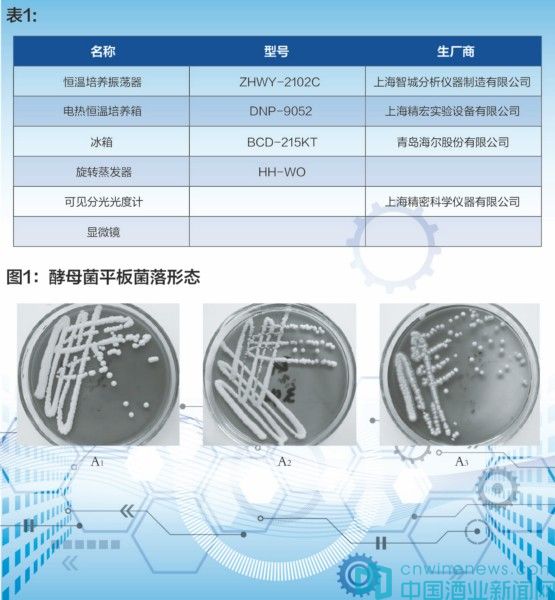

摘 要:本研究將從濃香型白酒廠提供的酒醅中分離酵母菌,對其生理生化特性和發(fā)酵特性進行鑒定,以期獲得可以工業(yè)應(yīng)用的酵母菌種。本試驗將酒醅菌液接種至YPD液體培養(yǎng)基中進行增菌培養(yǎng),然后將增菌培養(yǎng)液接種至含有氯霉素的麥芽汁瓊脂培養(yǎng)基。經(jīng)菌落特征、細胞形態(tài)、生理生化特征等方法,篩選出三株酵母菌。對三株酵母菌在30℃條件下進行發(fā)酵實驗,測酵母菌產(chǎn)酒精能力,并通過色譜分析測發(fā)酵液中產(chǎn)酯情況。
關(guān)鍵詞:白酒;酒醅;酵母菌
王友利
(江蘇御珍酒業(yè)有限公司)
白酒是我國特有的傳統(tǒng)蒸餾酒,在漫長的發(fā)展過程中形成了獨特的工藝和風味特征。酵母菌在原料淀粉質(zhì)的糖化,酒精的生成,香氣物質(zhì)的形成等方面都起著重要的作用,因此探討酵母微生物區(qū)系的變化,甚至特定發(fā)酵階段的種群結(jié)構(gòu)對白酒生產(chǎn)都有重要的指導意義。
為了比較準確地把握發(fā)酵過程中酒醅微生物區(qū)系的演變規(guī)律,為濃香型白酒的窖池發(fā)酵機理及物質(zhì)代謝過程的深入探討奠定良好的研究基礎(chǔ),以便弄清發(fā)酵過程中物質(zhì)變化趨勢與產(chǎn)品質(zhì)量及成分組成之間的相關(guān)關(guān)系,更好地指導濃香型白酒的發(fā)酵生產(chǎn),江南大學對醬香型白酒發(fā)酵窖池內(nèi)酵母菌系的結(jié)構(gòu)與功能進行了研究。本課題對濃香型窖池酒醅中微生物的分離培養(yǎng)、酒醅微生物的主要類群分析等方面進行了一些探索,以期為濃香型釀造機理奠定基礎(chǔ)。
酵母菌一般自然分布于高糖偏酸環(huán)境,適宜的生長溫度為25~30℃。酵母菌是兼性厭氧微生物,白酒發(fā)酵的主酵菌群在傳統(tǒng)白酒發(fā)酵過程中,當通氣充分時,酵母菌進行好氧呼吸,代謝能力強、速度快,菌體生長繁殖旺盛,在厭氧發(fā)酵階段的厭氣條件下,進行厭氧呼吸,經(jīng)厭氧乙醇發(fā)酵代謝途徑,發(fā)酵產(chǎn)生乙醇及相關(guān)發(fā)酵產(chǎn)物在白酒發(fā)酵過程中,酵母菌一般在厭氧發(fā)酵的前期,產(chǎn)生乙醇的能力較強,但隨著發(fā)酵過程的進行,酵母菌與環(huán)境生態(tài)因子之間的相互作用,酸性物質(zhì)也逐漸產(chǎn)生和積累,通常導致發(fā)酵環(huán)境的pH下降,進而使酵母菌生理代謝逐漸受到抑制,對發(fā)酵原料的轉(zhuǎn)化利用能力及乙醇的發(fā)酵生產(chǎn)能力也逐漸下降,甚至停止。
酒醅中酵母菌類以酵母菌屬為主,其次是有一定產(chǎn)香和產(chǎn)酒精能力的漢遜酵母和假絲酵母。酵母菌屬、漢遜酵母都屬原子囊菌亞綱、酵母目,假絲酵母是屬半知菌類的穩(wěn)球酵母科各屬。篩選出酵母菌對酵母菌進行分析,從而得出白酒中酵母菌的種類,從而更加了解酵母菌在發(fā)酵過程中的作用。
1、材料與方法
1.1 材料
1.1.1 菌株
酵母菌采樣于江蘇御珍酒業(yè)有限公司某車間小組的酒醅。
1.1.2 培養(yǎng)基
富集培養(yǎng)基:
YPD培養(yǎng)基:10g酵母浸膏,20g蛋白胨,20g葡萄糖,1000mL蒸餾水,121℃,滅菌20min;
酵母菌分離培養(yǎng)基:
麥芽汁瓊脂培養(yǎng)基:麥芽膏粉130g,瓊脂15g,氯霉素0.1g,1000mL蒸餾水,121℃,滅菌20min;
碳源基礎(chǔ)培養(yǎng)基:
硫酸銨2g,硫酸鎂0.2g,磷酸二氫鈉0.5g,氯化鈣0.1g,磷酸氫二鉀0.5g,1000mL蒸餾水;
氮源基礎(chǔ)培養(yǎng)基:
磷酸二氫鉀1.36g,氯化鈣0.005g,磷酸氫二鈉2.13g,葡萄糖10g,硫酸鎂0.2g,硫酸鐵0.0005g,1000mL蒸餾水。
1.1.3 主要儀器
見表1。
1.2 方法
1.2.1 酵母菌的分離
將白酒大叉10g放入50mL無菌水中,振蕩、搖勻,制備菌懸液,將菌懸液進行稀釋,按10%的接種量接種至YPD富集培養(yǎng)基中,在搖床中30℃,90rpm,進行12~24h的富集培養(yǎng),鏡檢培養(yǎng)基中是否有酵母,將富集培養(yǎng)后的酵母進行梯度稀釋10-1、10-2、10-3、10-4、10-5、10-6,吸取梯度為10-2、10-3、10-4、10-5、10-6的稀釋液200μL菌懸液涂布到含有氯霉素的麥芽汁瓊脂平板上,在恒溫培養(yǎng)箱中30℃,培養(yǎng)48~72h,對酵母菌進行分離。
1.2.2 酵母菌的純化
對分離麥芽汁瓊脂平板上的菌種進行鏡檢,挑去具有酵母菌特征外形的菌落進行檢測,檢測是否為酵母。鏡檢后,挑取經(jīng)鏡檢為酵母菌的平板的單菌落,進行劃線到麥芽汁瓊脂平板,在恒溫培養(yǎng)箱中30℃培養(yǎng)24h結(jié)合鏡檢,不斷進行劃線分離純化出單一酵母菌株。
1.2.3形態(tài)與培養(yǎng)特征
將酵母菌接種到Y(jié)PD液體培養(yǎng)基中,在恒溫培養(yǎng)箱中30℃,90rpm恒溫培養(yǎng)1-2d,觀察是否發(fā)酵、培養(yǎng)液是否渾濁,是否形成環(huán)或島,是否有沉淀及沉淀松緊情況,并制成水鏡片于顯微鏡下觀察,記錄酵母的無性繁殖與細胞的形狀,將酵母菌接種在麥芽汁瓊脂培養(yǎng)基上,在30℃培養(yǎng)3~4d,觀察其菌落形態(tài)。
1.2.4酵母菌理化指標測定
(1)碳源同化實驗
鑒定同化碳源種類有葡萄糖、麥芽糖、α-乳糖、蔗糖、棉籽糖、半乳糖、淀粉纖維二糖。
將上述一定量的碳源,分別加入到氮源基礎(chǔ)培養(yǎng)基中,滅菌115℃,20min。將經(jīng)活化后的酵母菌分別接種至上述含有不同碳源的培養(yǎng)基中,30℃條件下恒溫培養(yǎng),觀察其是否生長,且生長良好。結(jié)果觀察標準:將已培養(yǎng)數(shù)天的試管于混合振蕩器上搖動,使內(nèi)容物充分混勻。在一張白色卡片上畫一條約3/4mm 寬的線,將卡片緊靠試管,直對自然光觀察,如果能看到不連續(xù)線段的清晰邊緣,則記為+;如果溶液非常澄清,記為-,表示未有酵母生長,實驗設(shè)置三次重復,以不加碳源的培養(yǎng)基作為對照。
(2)氮源同化實驗
鑒定同化氮源種類為硝酸鉀、硫酸銨。
該實驗主要觀察分別以硝酸鉀、硫酸銨為唯一氮源時,酵母菌的生長情況。將氮源按照添加比例0.078%(w/w)加入到碳源基礎(chǔ)培養(yǎng)基中,滅菌115℃,20min,將活化后的酵母分別接種至含有不同氮源的培養(yǎng)基中,30℃條件下恒溫培養(yǎng)一周,結(jié)果觀察標準:將已培養(yǎng)數(shù)天的試管于混合振蕩器上搖動,使內(nèi)容物充分混勻。在一張白色卡片上畫一條約3/4mm 寬的線,將卡片緊靠試管,直對自然光觀察,如果能看到不連續(xù)線段的清晰邊緣,則記為+;如果溶液非常澄清,記為-,表示未有酵母生長,以不加氮源的培養(yǎng)基作為對照,實驗設(shè)置三次重復。
1.2.5酵母菌發(fā)酵
(1)酵母菌發(fā)酵
按照發(fā)酵培養(yǎng)基體積的 10%的接種量,接種到發(fā)酵培養(yǎng)基中。具體操作如下:
①菌種在YPD斜面上30℃活化兩次,接種于裝有100mL的12°Brix麥芽汁的250mL的錐形瓶中,30℃培養(yǎng)12~18小時;
②發(fā)酵使用500mL三角瓶,內(nèi)裝300mL發(fā)酵培養(yǎng)基,當細胞數(shù)目達到對數(shù)生長期時,將二級種子液接種30mL入發(fā)酵培養(yǎng)基中,8層紗布封口,30℃靜置培養(yǎng),靜置發(fā)酵5d;
③發(fā)酵完成后測定殘醪的酒精度。并對發(fā)酵液進行處理,供后期數(shù)據(jù)的處理與分析。
(2)酒精含量測定
將待測樣品中酒精用蒸餾法餾出,采用重鉻酸鉀-分光光度法于600nm波長處測定。精蒸餾采用干燥100mL容量瓶,準確量取發(fā)酵液100mL于500ml蒸餾瓶,用50mL蒸餾水分三次沖洗容量瓶.洗液并入蒸餾瓶。連接蛇形冷卻管,用前述取樣用100mL容量瓶做接收器(外加冰浴),開啟冷卻水緩慢加熱蒸餾,控制蒸餾速度,使蒸餾在30~40min內(nèi)完成。收集餾出液,當接近100ml刻度時,取下容量瓶,蓋塞,于20℃水浴中保溫30min,再補加水至刻度,混勻備用。
(3)色譜分析
發(fā)酵液蒸餾:用干燥100mL容量瓶,準確量取發(fā)酵液100mL于500ml蒸餾瓶,用50mL蒸餾水分三次沖洗容量瓶.洗液并入蒸餾瓶。連接蛇形冷卻管,用前述取樣用100mL容量瓶做接收器(外加冰浴),開啟冷卻水緩慢加熱蒸餾,控制蒸餾速度,使蒸餾在30~40min內(nèi)完成。收集餾出液,將餾出液進行色譜分析。
色譜柱為CP-WAX57CP,毛細血管柱(長度50m,內(nèi)徑0.25mm,膜厚0.2μm),柱溫采用程序升溫,初始溫度35℃,保持8min后以4℃/min升至75℃,保持2min,繼續(xù)以15℃/min升溫至180℃,保持2min,再以10℃/min升至210℃,保持13min,以進樣量1μL/min分流進樣,分流比50:1。載氣為氮氣,進氣量25mL/min,檢測器溫度300℃。
2、結(jié)果與討論
白酒的生產(chǎn)以泥窖窖池為基礎(chǔ),窖池中的多種微生物,特別是棲息于酒醅中的微生物左右著酒的產(chǎn)量和品質(zhì)。酵母菌在原料淀粉質(zhì)的糖化和酒精的生成,香氣物質(zhì)的形成等方面都起著重要的作用,是窖池發(fā)酵三大菌群之一。
在培養(yǎng)基中添加抗生素等抑菌物質(zhì),可以干擾細菌細胞壁的生物合成,減少菌液中細菌含量,從而提高酵母菌分離選育效率。
本實驗采用YPD富集培養(yǎng)基對酵母菌進行富集培養(yǎng)12-24小時,于此時吸取菌液涂布于含有氯霉素的麥芽汁瓊脂培養(yǎng)基,抑制細菌生長,提高酵母分離效率,選取三株單菌落進行劃線,結(jié)合鏡檢純化出單菌落酵母菌,斜面低溫保存。
2.1 酵母菌的分析
2.1.1形態(tài)與培養(yǎng)特征
(1)平板培養(yǎng)特征:見圖1。
上圖為酵母菌接種在麥芽汁瓊脂培養(yǎng)基上,在30℃培養(yǎng)2d后酵母菌的平板菌落形態(tài),由上圖知其中A1酵母菌,直徑1~4mm,圓形,乳白色,奶油狀,不透明,表面光滑,粘稠,有發(fā)酵香氣;A2酵母菌,圓形,直徑1~4mm,圓形,乳白色,奶油狀,不透明,表面光滑,粘稠,有發(fā)酵香氣;A3酵母菌,圓形,直徑1~3mm,圓形,乳白色,菌落表面干燥有褶皺,邊緣不整齊,中間凸起,無發(fā)酵香氣。

